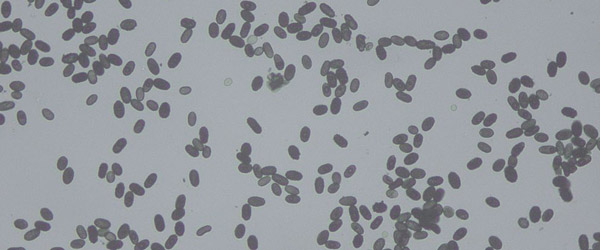
Stachybotrys

MOLD TESTING - HOME INSPECTION SERVICES

Yakima Valley Home Inspection Mold Testing
The presence of mold, water damage, or musty odors should be addressed immediately. In all instances, any source(s) of water must be stopped and the extent of water damage determined. Water damaged materials should be dried and repaired. Environmental sampling is then recommended to determine the type and extent of the existing mold. Mold is a structural, health and environmental problem. Some mold defects can't be seen and will only be detected through sampling.
TYPES OF MOLD
Stachybotrys
This mold is a slow growing fungus. It grows well on high cellulose materials like straw, grass, sawdust, lumber and drywall plaster board or ceiling tiles. Like a fungi, it requires a moisture source. About15 species of Stachybotrys can be found worldwide, but it is most common in the Western U.S. Generally, this mold grows where the relative humidity is above 55 percent or the material is water-saturated. In studies conducted in North America, Stachybotrys was found in 2 to 3 percent of home environments sampled.
Disease - Stachybotrys atra spores are breathed into the lungs. Persons with chronic exposure to the toxin report cold or flu-like symptoms with sore throat, diarrhea, headaches, fatigue, dermatitis, intermittent local hair loss and general malaise. The toxins may also suppress the immune system. Infants may be particularly susceptible to the effects of these inhaled mycotoxins because their lungs are growing very rapidly. Mycotoxins are lipid-soluble and are readily absorbed by the intestinal lining, airways, and skin.
How to Control Stachybotrys - Homes and buildings with water damage should be repaired, the source of moisture eliminated, and all moldy material should be removed. Reduce humidity in the home with adequate venting of appliances such as dryer vents bathroom and kitchen cooking vents, etc. Even "excessively sealed" homes with inadequate air exchange can cause high humidity inside from showers, cooking, laundry, etc. Although some molds can be killed by cleaning the moldy surface with chlorine, Stachybotrys often has a germ, mycelium that is buried inside the water-damaged surface that may be inaccessible to chlorine. It is best to remove all of the water-damaged material.

Penicillium
Some Penicillium species are fairly common indoor fungi, even in clean environments. This particular specie of fungi can proliferate in abundance in indoor environments. P. species can be found at the sub-basement levels offices and rooms, in libraries, auditorium, storage room of paper materials and also in ventilation systems. Some P.species can produce small, nondescript conidia and complex mixtures of metabolites that are more or less toxic.
Like all other molds, spores have the highest concentrations of mycotoxin, although the vegetative portion of the mold, the mycelium, can also contain the poison.
Disease - Exposure to the various penicillium toxin can result in the following ill health effects:- Patulin, a toxin from P. expansum: cytotoxic and/or carcinogenic
- Citrinin, a toxin from P. citrinum, - expansum & - viridicatum: nephrotoxic
- Ochratoxin, a toxin from P. cyclopium & -viridicatum: nephrotoxic

Aspergillus
A group of molds which is found everywhere worldwide, especially in the autumn and winter in the Northern Hemisphere. Only a few of these molds can cause illness in humans and animals. Most people are naturally immune and do not develop disease caused by Aspergillus. However, when disease does occur, it takes several forms.
Disease - The type of diseases caused by Aspergillus are varied, ranging from a ‹allergy-type illness to life-threatening generalized infections. Diseases caused by Aspergillus are called aspergillosis. The severity of aspergillosis is determined by various factors but one of the most important is the state of the immune system of the person.
Allergic Bronchopulmonary Aspergillosis (ABPA) - This is a condition which produces an allergy to the spores of the Aspergillus moulds. It is quite common in asthmatics; up to 20% of asthmatics might get this at some time during their lives.
Aspergilloma - The type of diseases caused by Aspergillus are varied, ranging from a ‹allergy-type illness to life-threatening generalized infections. Diseases caused by Aspergillus are called aspergillosis. The severity of aspergillosis is determined by various factors but one of the most important is the state of the immune system of the person.
Aspergillus Sinusitis - The type of diseases caused by Aspergillus are varied, ranging from a ‹allergy-type illness to life-threatening generalized infections. Diseases caused by Aspergillus are called aspergillosis. The severity of aspergillosis is determined by various factors but one of the most important is the state of the immune system of the person.
Invasive Aspergillosis - The type of diseases caused by Aspergillus are varied, ranging from a ‹allergy-type illness to life-threatening generalized infections. Diseases caused by Aspergillus are called aspergillosis. The severity of aspergillosis is determined by various factors but one of the most important is the state of the immune system of the person.

Poria
Two major differences between poria and ordinary decay fungi are that ordinary decay fungi require the structure to provide the water (green wood, rain and plumbing leaks, condensation), while poria provides its own water through rhizomorphs connected to moist soil outside the structure, and poria dies quickly when deprived of water, while ordinary decay fungi usually just go dormant. These differences make both the detection and control of poria very different from those of ordinary decay fungi. An inspector who does not accurately diagnose poria infection can make there company responsible for repairing extensive decay, including that already repaired, within less than one year; or, in the extreme, razing and rebuilding the entire structure.
